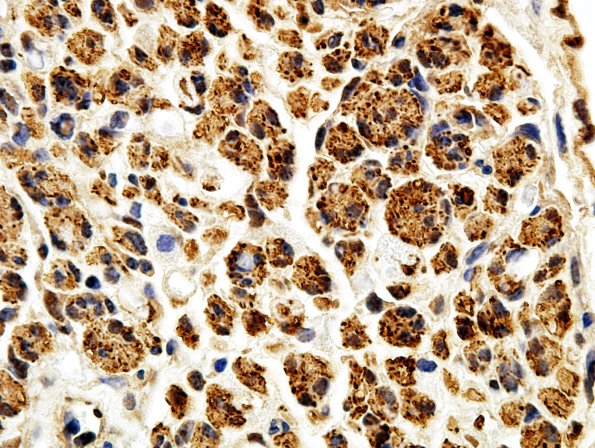
1B1 Regeneration NF (Case 1) aA

Table of Contents
Washington University Experience | PERIPHERAL NEUROPATHY | 4 AXONAL DEGENERATION | 1 H&E & IHC | 1B1 Regeneration NF (Case 1) aA
1B1-3 These are Schwann cells with degenerating axonal debris and early regeneration of axons and macrophages with axonal debris. (NF IHC)